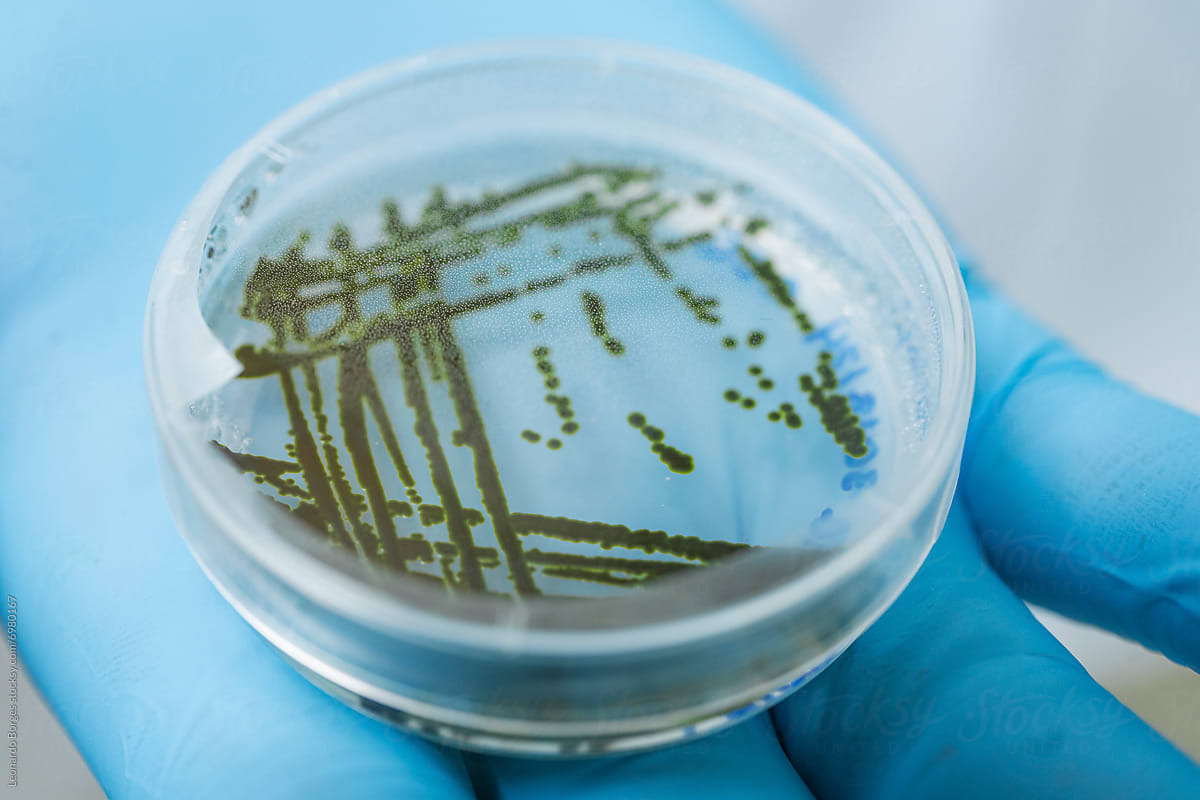

Fix the root.
Grow the future.
Root is clinically validated functional medicine,
designed for people and delivered at scale.





Care beyond coverage.
Root is the functional medicine benefit for self-funded employers, reversing chronic conditions, reducing claims, and helping employees achieve lasting health.
Uncover the root cause of chronic conditions.
We address the root — not just the symptoms — of chronic conditions to help people get and stay well.
Get expert insights from doctors and dietitians.
Root doctors and dietitians are experts in functional medicine, providing members with guidance and support.
Fuel wellbeing with testing and supplements.
Members gain access to discounted lab panels, third-party, professional-grade supplements, and tailored guidance.
We've helped thousands of people reverse their chronic disease symptoms.






Business impact you can feel.
utilization rate over other health benefits
employees report results in 90 days
reduction in annual healthcare costs
Get the outcomes
your organization needs.
Uncover key insights to measure return on investment
Whole body lab testing and insights
Empower your people to perform at their fullest potential
Lower healthcare costs and reduce claims
$89,000
saved costs
Seamlessly incorporate functional medicine into your benefits offering
Save up to 90% on conventional lab tests
Find labs, insights, and advice in one convenient platform
left a message
reviewed your test results
Unlock discounts on supplements
Work with credentialed doctors and dietitians
Join a community full of people on their own healing journeys

Start with a Root Cause Panel.
Our Root Cause Panel is a full-spectrum snapshot, allowing us to gain critical whole-body health insights and set benchmarks for care.
A high-tech, low-lift functional medicine benefit.
Schedule a virtual visit with a doctor.
Set up your first virtual appointment with a Root functional medicine doctor.
Messages
Appointments
Your Root doctor has recommended these lab tests.
Your Root Symptom Score
This is your current Root Symptom Score. We will save it and track it throughout your Root journey to measure your progress over time.
Join a Root challenge to unlock motivation.
Smoothie Challenge

A benefit that
actually benefits.








